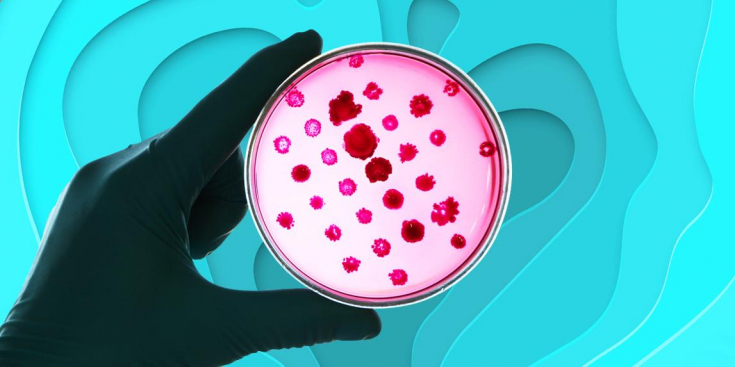
Как увеличивает срок жизни и лечит  биохакинг

Біохакінг – метод, який у багатьох на слуху, але мало хто розуміє, що саме він являє собою.
По суті, це комплекс заходів для покращення здоров'я організму та підвищення його життєвих показників. Тільки для цього потрібно не тільки правильне харчування та спорт, а й низку препаратів, які підбирає лікар.
Наслідники методу кажуть, що можна буквально стати суперменом, продовжити молодість, покращити роботу мозку.
Що для цього потрібно зробити? Редакція estet-portal.com розповість все про біохакінг.
- Що таке біохакінг і на що він впливає
- Біохакінг: з чого почати покращення себе
- Біохакінг - чи небезпечний:думка лікарів
Що таке біохакінг і на що він впливає
Біохакінг – це радикальна система оздоровлення та контролю здоров'я. Це не лікування, а покращення того, що вже є.
Дехто порівнює цей напрямок з можливістю стати суперменом, людиною з новими можливостями. Як цього досягти? На основі проведеної діагностики ви змінюєте харчування, режим сну, фізичні навантаження.
Підписуйтесь на нас у Instagram
Все це має сприяти збереженню молодості, покращенню роботи організму. Можна не просто стати здоровішим, а підвищити якісь окремі показники, наприклад, витривалість, роботу мозку, привабливість тощо. І в результаті на порядок зробити своє життя привабливішим для себе самого.
Однак багато лікарів вважають біохакінг крайністю. Тобто покращувати організм за допомогою спорту та правильного харчування, прийому вітамінів –. це добре. А ось робити це за допомогою медикаментів – небажано.
Біохакінг: з чого почати покращення себе
Основа біохакінгу – це діагностика. Саме з неї і треба розпочинати. Для цього потрібно здати не лише клінічні аналізи сечі та крові. Важливо визначити кількість антиоксидантів, вільних радикалів, мікроелементів та металів, вітамінів.
Така діагностика проводиться на самому початку, а потім періодично повторюється для контролю та коригування прийому препаратів.
Що ви отримаєте в результаті першої діагностики? Спеціаліст на основі даних розпише рекомендації – наприклад, спати певну кількість годин, збільшити вживання конкретних продуктів, приймати препарати для нормалізації рівня вітамінів< тощо.
Загалом біохакінг проводиться в дев'яти напрямках:
1. Харчування – Ви отримуєте індивідуальний раціон залежно від особливостей організму.
2. Фізична активність – розклад занять, вправи для здоров'я та краси тіла.
3. Гормональний статус – перевірка рівня гормонів та їх коригування залежно від віку, статі та інших факторів.
4. Виведення токсинів – проводиться очищення організму, його захист від негативних факторів довкілля.
5. Генетика – дослідження дозволяють визначити генетичну схильність до хвороб та різних негативних змін.
6. Нормалізація режиму сну.
7. Косметологія – покращення стану шкіри, волосся та нігтів.
8. Робота мозку – покращення уваги, мислення, розвиток творчих здібностей.
9. Корекція емоційної сфери, захист від стресу.
При цьому біохакінг не є лікуванням. По суті, Ви станете здоровішими, покращите показники організму, роботу внутрішніх органів, зовнішній вигляд.
Подібний комплекс заходів вимагає чималих фінансових витрат – Тільки в медичні обстеження потрібно ґрунтовно вкластися. Пізніше потрібно буде купувати БАДи та медичні препарати.
Також для контролю стану організму та режиму дня потрібно буде користуватися електронними гаджетами та мобільними програмами. Але ті, хто скористався цією методикою, стверджують, що воно того варте!
Біохакінг – це стиль життя. Рекомендацій потрібно дотримуватися постійно і без зупинок, щоб добитися бажаного результату.
Біохакінг – Чи небезпечний він: думка лікарів
Головна ідея біохакінгу – поліпшення продуктивності організму, збереження молодості та довголіття. Однак, як і будь-яка ідея, ця теж має свої ризики та недоліки.
Так, лікарі попереджають про такі можливі небезпеки:
• коригувати метаболізм за допомогою потужних препаратів загрожує збоями в роботі організму – до цього потрібно підходити обдумано;
• звикання до препаратів – їх потрібно буде використовувати все життя, і у разі скасування організму буде без них складно;
• обережним слід бути з прийомом гормональних засобів;
• безвуглеводна дієта – одна з базових умов біохакінгу, але без цукру організму складно нормально працювати, тому краще просто обмежити вживання швидких вуглеводів.
У будь-якому випадку, біохакінг – це не панацея від старості чи хвороб. Тому до змін у роботі організму потрібно підходити з розумом, не пороти гарячку, приймати рішення виважено. І лікаря вибирати потрібно ретельно, щоб не стати жертвою шарлатана.
Для призначення схеми лікування лікар має провести безліч аналізів, отримати детальні дані щодо стану Вашого організму.
Якщо Вам провели пару діагностик і на їх підставі виписують препарати, то перед Вами – ndash; шарлатан.
Біохакінг – це поліпшення стану здоров'я та показників організму за рахунок зміни способу життя та прийому препаратів. В результаті підвищується рівень життя, самовідчуття, людина стає більш продуктивною та активною.
Звичайно, не останню роль відіграє можливість збереження молодості та краси.
Методи біохакінгу – досить радикальні, адже включають прийом препаратів, а не лише зміну способу життя.
Якщо вірити тим, хто скористався цією системою заходів, зміни – виключно позитивні.
Але лікарі попереджають і про ризики для організму, а також можливі негативні наслідки, якщо звернутися до некомпетентного фахівця.
Розпорядок дня геніїв: секрети успіху
Вам може бути цікаво: Тест для перевірки пам'яті.

Додати коментар